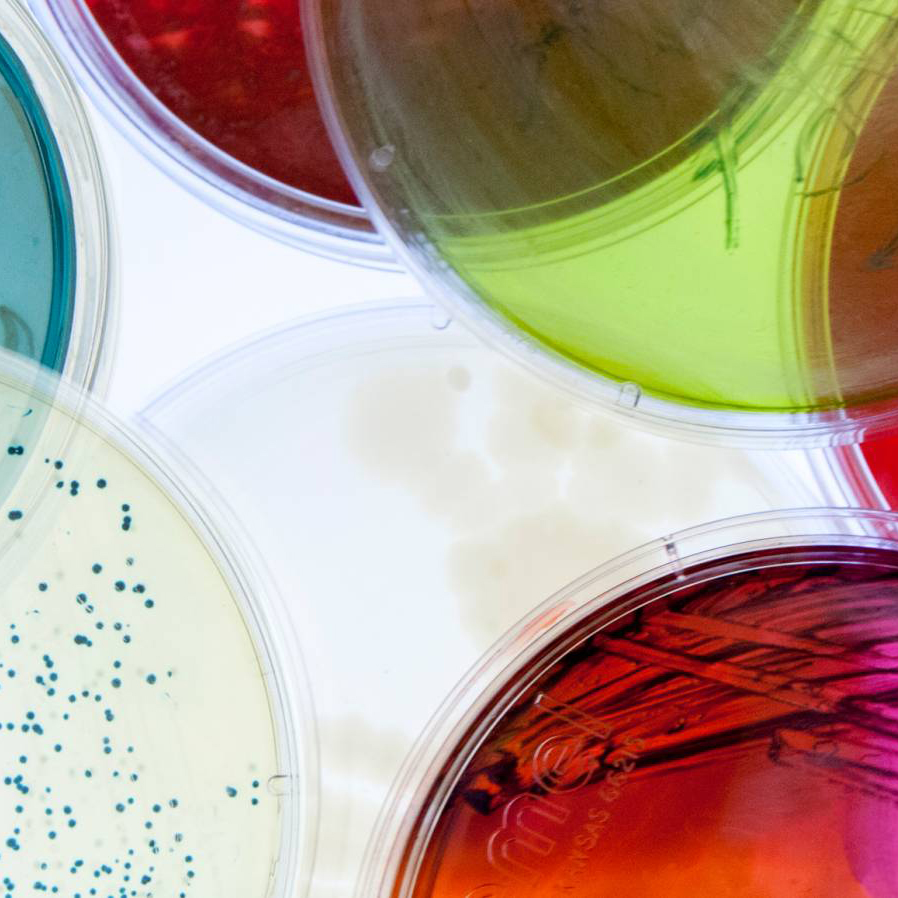

Experience Science, the Arts, & Culture
The Rockefeller University is an acknowledged cultural center in New York City, offering opportunities throughout the academic year for benefactors and the public to hear from the world’s leaders in science and the arts. The University’s outreach programs include lay-language science lectures, musical performances, and educational initiatives for individuals of all ages.